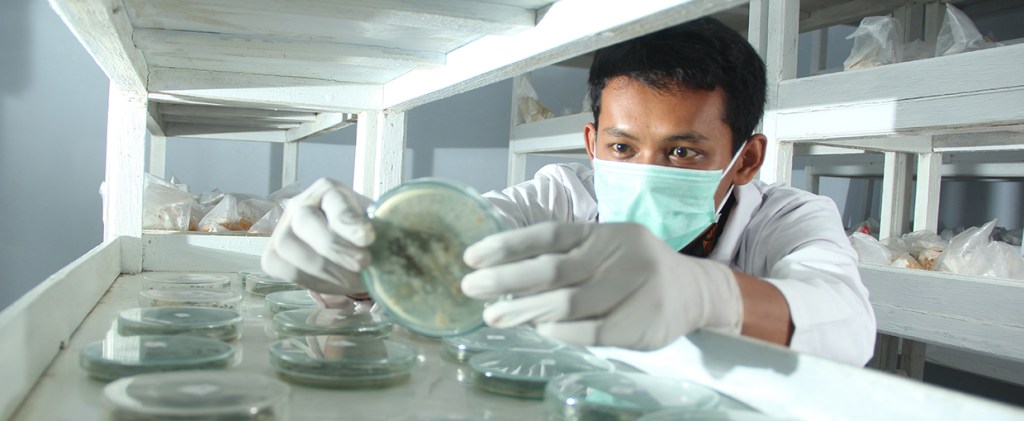

Finance Analyst
Deskripsi Pekerjaan
Melakukan analisa terkait :
– Management Reporting
– Data Analysis
– Business Forecasting
Persyaratan:
– Lulusan S1 Akuntansi, Manajemen Bisnis, Ekonomi
– Fresh Graduate dipersilahkan melamar
– Bersedia ditempatkan di Head Office PT Astra Agro Lestari, Jakarta Timur
Accounting Analyst
Deskripsi Pekerjaan:
– Mengerjakan end-to-end laporan terkait Keuangan Interim Triwulanan, Audit, Atestasi KPPK
– Melakukan input data terkait report Profit/Loss dan HS Konsolidasi
Persyaratan:
– Lulusan S1 Akuntansi, Ekonomi
– Menguasai Program Office
– Fresh Graduate dipersilahkan melamar
Asisten SHE
Deskripsi Pekerjaan
– Mengelola dan mengontrol pemakaian APD di lingkungan perusahaan sesuai dengan kebijakan K3 yang berlaku
– Memastikan seluruh area perusahaan terhindar dari bahaya kecelakaan kerja
– Menyusun program keselamatan kerja dan pengelolaan lingkungan yang sehat sesuai dengan standar K3
– Mensosialisasikan keselamatan kerja kepada seluruh karyawan untuk menciptakan kesadaran K3
Persyaratan
– Lulusan S1 Teknik Lingkungan, Kesehatan dan Keselamatan Kerja
– Bersedia ditempatkan di Sulawesi, Kalimantan, dan Sumatera
– Fresh Graduate dipersilahkan melamar
Pabrik Refinery
Jobdesc:
– Bertanggung jawab atas proses produksi & kualitas produksi
– Memastikan ketersediaan stock bahan baku & bahan penunjang
Requirement:
– Lulusan S1 Teknik Kimia
– Fresh graduate di persilahkan melamar
– Memiliki pengalaman dan pemahaman dalam industri sawit menjadi nilai tambah
– Bersedia di tempatkan di area Sulawesi
Research & Development
Jobdesc:
– Merancang penelitian terkait agronomi, tanah, mikrobiologi, breeding ataupun hama dan penyakit
– Melakukan penelitian yang telah disetujui pada rapat peneliti R&D atau disetujui oleh BOD.
– Pengumpulan dan verifikasi data.
Requirement:
– Lulusan S1 Ilmu Tanah, Agronomi & Hortikultura
– Fresh graduate dipersilahkan melamar
– Memiliki ketertarikan di bidang riset maupun lapangan
– Bersedia di tempatkan di seluruh wilayah kerja PT Astra Agro Lestari (Sumatera, Kalimantan, Sulawesi)